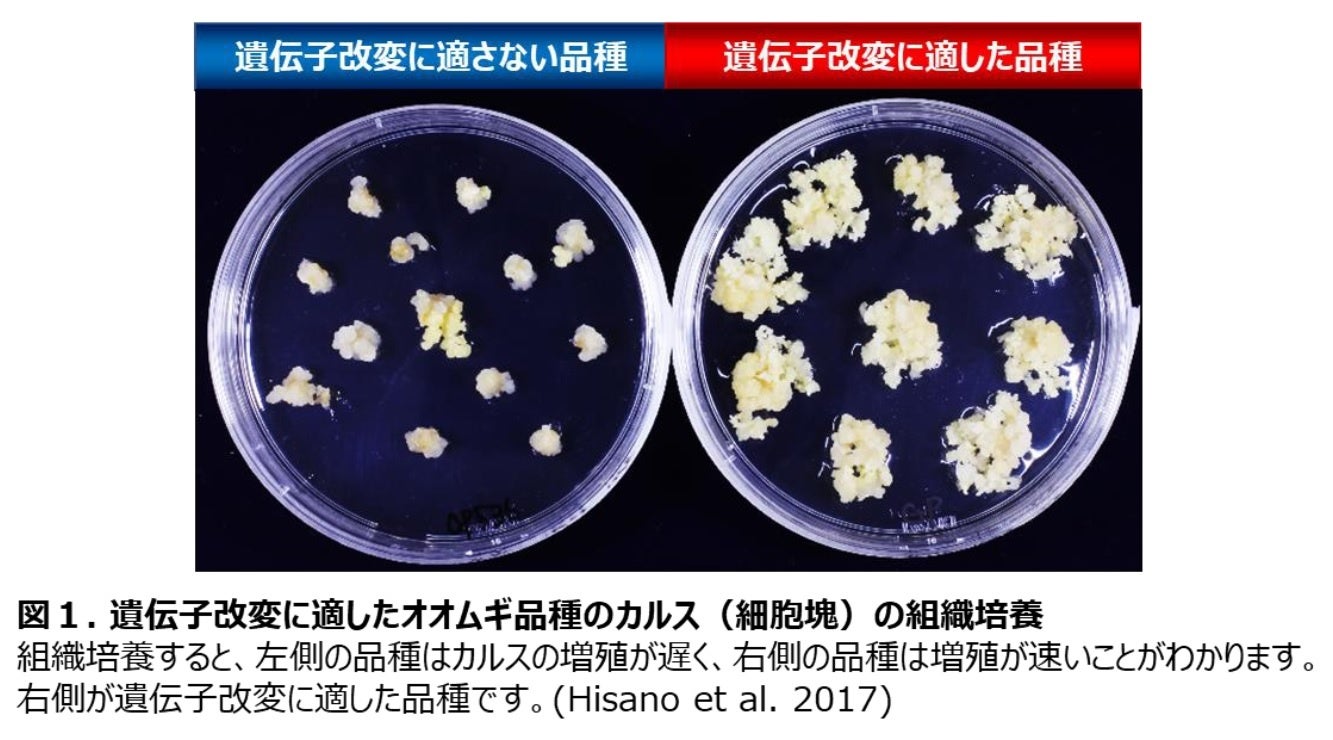

◆概 要
国立大学法人岡山大学(本部:岡山市北区、学長:槇野博史)の文明動態学研究所(RIDC)は、2021(令和3)年に開所された岡山大学で4つ目の研究所であり、人文・社会科学系でははじめての研究所です。
RIDCでは、「RIDCマンスリー研究セミナー」を開催し、RIDCにかかわる教員の研究成果や進行中のプロジェクトの進捗状況などを自由に報告し、語り合う場にしたいと考えています(セミナーは、一般公開にする場合とセミクローズドで行う場合があります)。
第19回となるRIDCマンスリー研究セミナーを下記の通りオンラインで開催します。
ご興味、ご関心のある方ならば、どなたでもご参加いただけます。みなさまのご参加を心よりお待ちしております。
【日 時】
2023年 1月 25日(水) 12:00 ~ 13:00
【題 名】
古墳時代における金属製武器の入手・保有・共有とその歴史的意義
【概 要】
古墳時代(3世紀中葉~7世紀初頭)は、日本列島各地において古墳が有力者の身分表示として数多く造られることによって特徴づけられる。またこれらの古墳がヤマト政権との社会政治的関係の中で構築され、その政治的関係の証しとして、銅鏡や金属製武器などがヤマト政権から各地の有力者へ配布されていたと考えられている。
このように、古墳から出土する金属製武器の多くは、地域の有力者とヤマト政権との直接的な関係の物的証拠として捉えられてきた。
一方で近年、金属製武器の多様な来歴が注目されるようになってきている。従来重視されてきたヤマト政権からの配布のみならず、有力者同士の授受や在地生産も指摘されている。
本発表では、生産と流通の多様性と重層性に注目し、古墳時代における金属製武器の入手背景とその歴史的意義を再検討したい。
【スピーカー】
ライアン ジョセフ氏(岡山大学文明動態学研究所 特任助教)
【開催方法】
オンライン(ご参加いただくにはZoomのご利用が必要となります)
【対象者】
どなたでもご参加いただけます
【参加費】
無 料
【主 催】
岡山大学文明動態学研究所(RIDC)
【お申込方法】
2023年1月24日(火)12:00までに、下記URLからお申込みください。
折り返し、参加用URLをお送りします。
https://forms.gle/HwnHTsMMdHXas5Dh8
【ポスター】
https://ridc.okayama-u.ac.jp/wp-content/uploads/2022/12/RIDC_seminar_202301.pdf

◆参考:RIDCマンスリー研究セミナー
・【岡山大学文明動態学研究所】第3回RIDC マンスリー研究セミナー「日本史研究と地域史研究のはざま―生存の「関係・空間」の歴史学―」
https://youtu.be/C2XefIGOQiQ
・【岡山大学文明動態学研究所】第6回RIDCマンスリー研究セミナー「プリント化する伝統織物-インドネシア、バリ島紋織をめぐるオーセンティシティとアイデンティティ-」 の録画配信を開始しました
https://prtimes.jp/main/html/rd/p/000000394.000072793.html
・【岡山大学文明動態学研究所】「経済状況が主観的ウェルビーイングに与える影響 -年齢階級・都道府県別クロス・セクション分析-」の録画配信を開始しました
https://prtimes.jp/main/html/rd/p/000000686.000072793.html
・【岡山大学文明動態学研究所】「「モノのやりとり」をめぐる認識の齟齬ともつれあい ートンガにおける他者接触の事例からー」の録画配信を開始しました
https://prtimes.jp/main/html/rd/p/000000702.000072793.html
・【岡山大学文明動態学研究所】「入所者の住宅からみた長島愛生園の歴史」の録画配信を開始しました
https://prtimes.jp/main/html/rd/p/000000802.000072793.html
・【岡山大学文明動態学研究所】「「家族や子どもに迷惑をかけたくない」という思いとは何か?-〈迷惑〉研究プロジェクトの軌跡と展望-」の録画配信を開始しました
https://prtimes.jp/main/html/rd/p/000000883.000072793.html
・【岡山大学文明動態学研究所】「ぶどう輸出の現状と消費者の評価 -台湾のアンケート調査から-」の録画配信を開始しました
https://prtimes.jp/main/html/rd/p/000001045.000072793.html

◆参考情報
・岡山大学文明動態学研究所(RIDC)
https://ridc.okayama-u.ac.jp/
・【岡山大学】岡山大学文明動態学研究所開所式を挙行
https://prtimes.jp/main/html/rd/p/000000063.000072793.html
・【岡山大学】文明動態学研究所 キックオフ・シンポジウム「パンデミックと文明 -感染症と向き合う過去から未来へ-」〔4月14日(水)開催〕
https://prtimes.jp/main/html/rd/p/000000053.000072793.html
・【岡山大学】岡山大学文明動態学研究所『文明動態学』Vol.1が刊行されました
https://prtimes.jp/main/html/rd/p/000000504.000072793.html
・【岡山大学文明動態学研究所】国際シンポジウム「ベーリンジア:ユーラシアからアメリカへの人類の拡散」の動画を公開しました
https://prtimes.jp/main/html/rd/p/000000998.000072793.html


岡山大学文明動態学研究所(RIDC)が所在する岡山大学津島キャンパス(岡山市北区)
◆本件お問い合わせ先
岡山大学文明動態学研究所(RIDC)
〒700-8530 岡山県岡山市北区津島中3丁目1番1号 岡山大学津島キャンパス
E-mail:ridc◎okayama-u.ac.jp
※◎を@に置き換えて下さい。
TEL:086-251-7442
https://ridc.okayama-u.ac.jp/
<岡山大学の産学連携などに関するお問い合わせ先>
岡山大学研究推進機構 産学官連携本部
〒700-8530 岡山県岡山市北区津島中1丁目1番1号 岡山大学津島キャンパス 本部棟1階
E-mail:sangaku◎okayama-u.ac.jp
※◎を@に置き換えて下さい。
TEL: 086-251-8463
https://www.orsd.okayama-u.ac.jp/
岡山大学メディア「OTD」(アプリ):https://prtimes.jp/main/html/rd/p/000000011.000072793.html
岡山大学メディア「OTD」(ウェブ):https://prtimes.jp/main/html/rd/p/000000215.000072793.html
岡山大学SDGsホームページ:https://sdgs.okayama-u.ac.jp/
岡山大学Image Movie (YouTube):https://youtu.be/pKMHm4XJLtw
「岡大TV」(YouTube):https://www.youtube.com/channel/UCi4hPHf_jZ1FXqJfsacUqaw
産学共創活動「岡山大学オープンイノベーションチャレンジ」2022年12月期共創活動パートナー募集中:
https://prtimes.jp/main/html/rd/p/000001066.000072793.html
岡山大学『THEインパクトランキング2021』総合ランキング 世界トップ200位以内、国内同列1位!!
https://prtimes.jp/main/html/rd/p/000000070.000072793.html
岡山大学『大学ブランド・イメージ調査2021~2022』「SDGsに積極的な大学」中国・四国1位!!
https://prtimes.jp/main/html/rd/p/000000373.000072793.html
岡山大学『企業の人事担当者から見た大学イメージ調査2022年度版』中国・四国1位!!
https://prtimes.jp/main/html/rd/p/000000122.000072793.html

国立大学法人岡山大学は、国連の「持続可能な開発目標(SDGs)」を支援しています。また、政府の第1回「ジャパンSDGsアワード」特別賞を受賞しています